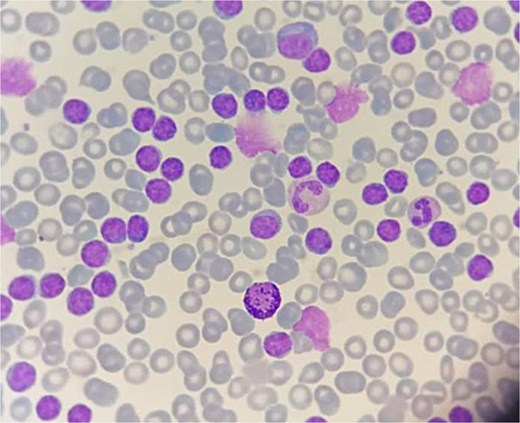
Peripheral blood smear showing abnormal lymphocytes with numerous gumprecht shadows.

-
PDF
- Split View
-
Views
-
Cite
Cite
Mohammed Hassani, Tarik Deflaoui, Mohammed Frikal, Anas Derkaoui, Yassir Akil, Mohammed Lakhloufi, Nada Ouahabi, Safae Ouahabi, Abdelali Guellil, Rachid Jabi, Mohammed Bouziane, Acute pancreatitis revealing adult lymphocytic leukemia in a patient with double cystic duct: a rare case report, Journal of Surgical Case Reports, Volume 2025, Issue 7, July 2025, rjaf580, https://doi.org/10.1093/jscr/rjaf580
Close - Share Icon Share
Abstract
Chronic lymphocytic leukemia (CLL) is an indolent B-cell lymphoproliferative disorder often discovered incidentally through routine blood tests. Acute pancreatitis (AP) is a common abdominal emergency, typically of biliary or alcoholic etiology. We report an unusual case of a 63-year-old woman presenting with AP due to biliary lithiasis, which led to the incidental diagnosis of CLL. Notably, intraoperative findings revealed a rare anatomical anomaly: double cystic duct. This case underscores the importance of systematic etiological exploration in AP and highlights potential surgical implications of biliary anomalies in oncologic and inflammatory settings.
Introduction
Chronic lymphocytic leukemia (CLL) is the most prevalent leukemia in adults in Western countries, characterized by the clonal proliferation of mature B lymphocytes [1, 2]. While often asymptomatic, it may occasionally present through atypical manifestations. Acute pancreatitis (AP), conversely, is an inflammatory condition commonly triggered by gallstones or alcohol, with rare hematologic origins [3, 4].
The occurrence of AP as the first manifestation of a hematologic malignancy is exceedingly rare. Cases of leukemia-induced pancreatitis, either through leukemic infiltration or secondary mechanisms, are exceptional in the literature [4, 5]. We present a rare association of CLL diagnosed during the etiological workup of AP in a patient with an intraoperative discovery of a duplicated cystic duct—an anomaly with potential clinical consequences [6, 7].
Case presentation
A 63-year-old woman with no significant past medical or surgical history was admitted for acute epigastric pain with vomiting, evolving for 48 hours. She reported no alcohol intake, drug use, or history of autoimmune disease.
Clinical examination revealed a conscious, hemodynamically stable patient with epigastric tenderness and no signs of peritonitis.
Laboratory findings were notable for:
Elevated serum lipase (eight times the upper normal limit)
Leukocytosis with marked lymphocytosis (102–130/μl)
CT scan (Day 3 of symptoms) revealed:
An enlarged, heterogeneously enhancing pancreas (mostly head and body)
Peripancreatic fat stranding and necrotic collections consistent with Balthazar grade E pancreatitis
Peripheral smear showed a monomorphic population of mature lymphocytes with high N/C ratio, basophilic cytoplasm, clumped chromatin, and numerous Gumprecht shadows (Fig. 2). Flow cytometry confirmed a CD5+, CD23+, CD19+ monoclonal B-cell population, consistent with CLL [2, 8].
Etiological workup excluded alcohol, hypercalcemia, hypertriglyceridemia, drug-induced AP, and autoimmune causes. Abdominal ultrasound revealed biliary lithiasis without bile duct dilatation. Hence, lithiasic pancreatitis was retained as the immediate cause.
The patient was managed in the intensive care unit with:
IV hydration, analgesia, and thromboprophylaxis
Early initiation of CLL-targeted chemotherapy
Transfer to internal medicine for hematologic monitoring
Surgery was performed after stabilization for elective cholecystectomy (Fig. 1). Intraoperatively, a double cystic duct was identified and managed successfully (Fig. 3). Pathology confirmed chronic cholecystitis with no malignancy.

Cholecystectomy specimen showing the three elements: Cystic artery (3) and two cystic ducts (1, 2).
Peripheral blood smear showing abnormal lymphocytes with numerous gumprecht shadows.

Intraoperative image showing three elements: Cystic artery (3) and two cystic ducts (1, 2).
Discussion
CLL is a mature B-cell malignancy diagnosed based on sustained lymphocytosis (>5 × 109/L) and flow cytometric immunophenotyping [1, 2, 8]. Cytologic examination typically reveals small, mature lymphocytes with coarse chromatin and Gumprecht shadows [8]. Though often discovered incidentally, CLL may rarely be associated with systemic manifestations or even paraneoplastic complications.
In rare reports, leukemic infiltration of the pancreas or secondary metabolic disturbances have been implicated in AP [4, 5]. In our case, the pancreatitis was biliary in origin, and the association with CLL appeared coincidental, though revealing.
Moreover, the intraoperative discovery of a double cystic duct, a rare anatomical variant, added complexity to the surgical approach. This condition has been documented in the literature as a potential source of bile duct injury or misdiagnosis [6, 7]. Preoperative recognition is rare, and the anomaly is often identified intraoperatively or postoperatively through imaging or complications [9, 10].
Conclusion
This case illustrates an uncommon clinical scenario where acute lithiasic pancreatitis unmasked chronic lymphocytic leukemia, with the additional finding of a duplicated cystic duct. While the association between AP and CLL may be fortuitous, awareness of such atypical presentations is crucial. Furthermore, congenital biliary anomalies, though rare, must be recognized and managed appropriately during surgery to avoid iatrogenic injuries.
Conflict of interest statement
None declared.
Funding
None declared.